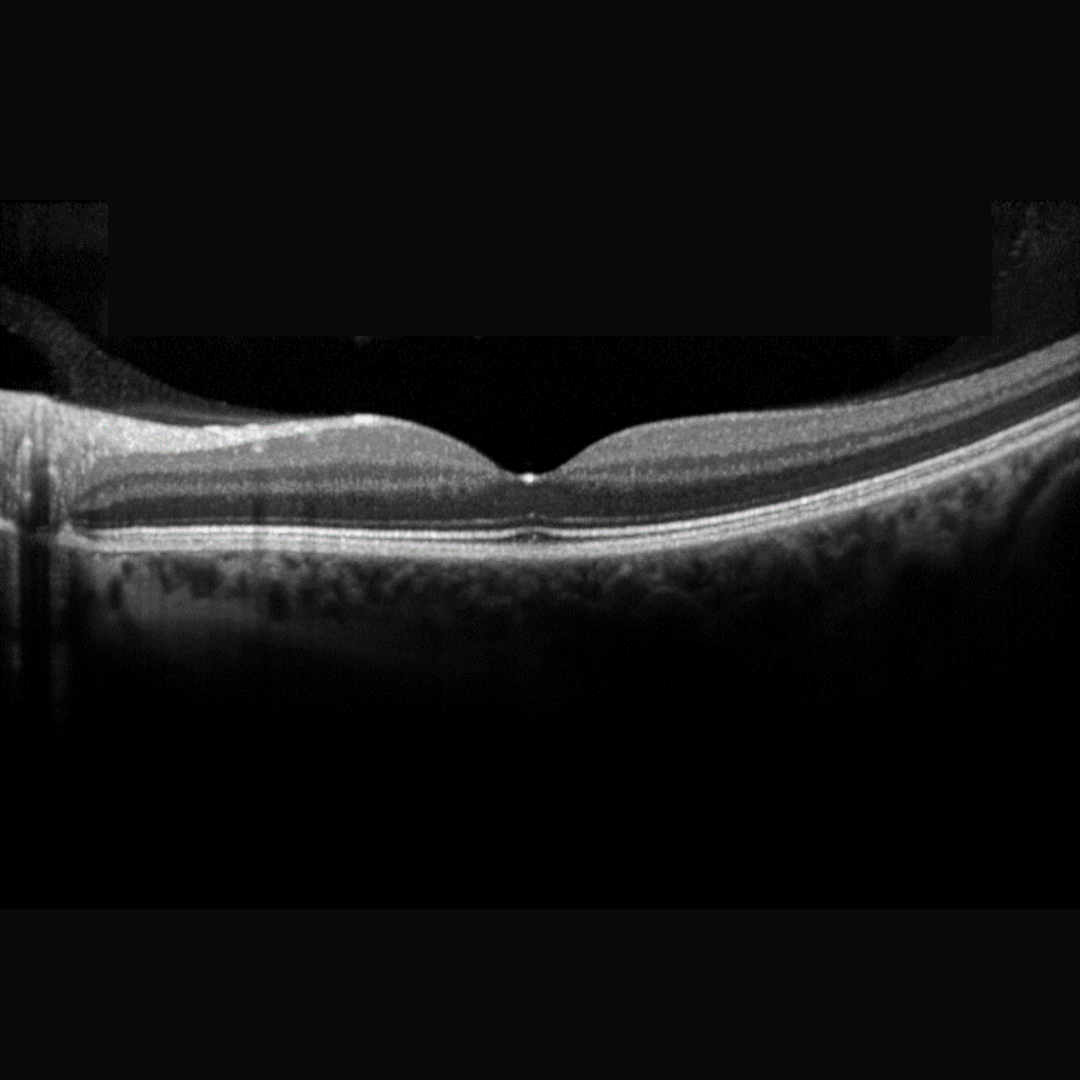

Normal Vitreoretinal Attachments
Vitreous adhesion to the retinal internal limiting membrane (ILM) is strongest at the vitreous base and margins of the optic disc. Other attachments exist at the macula and posterior lens surface and there are weak attachments along the superficial retinal vessels.
This chapter will look at peripheral lesions that create unusually strong attachments between the vitreous and retina, potentially causing tractional changes and thereby predisposing the patient to retinal breaks.